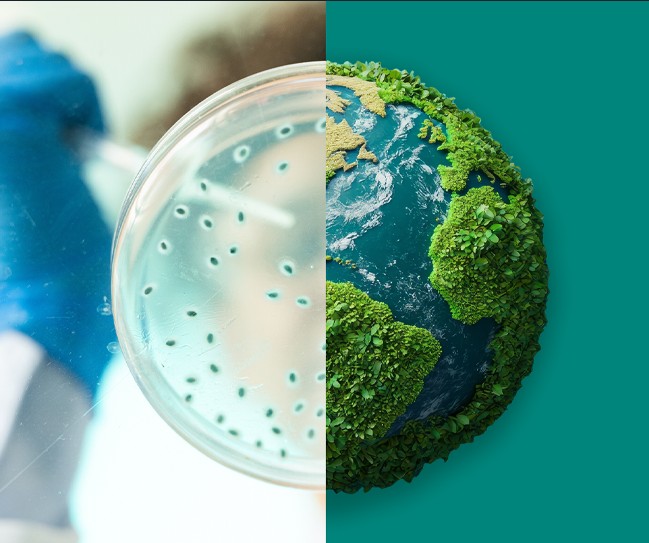

Βιώσιμη Ανάπτυξη
Λειτουργούμε με υπευθυνότητα καθημερινά για να βελτιώσουμε την υγεία των ανθρώπων και των ζώων, τώρα και στο μέλλον.
Purpose for Progress Impact Report 2024/2025
Purpose for Progress Report Summary 2024/2025
Η βιωσιμότητα είναι κεντρικής σημασίας για το πώς δραστηριοποιούμαστε
Η βιωσιμότητα είναι κεντρικής σημασίας για το πώς δραστηριοποιούμαστε
Από την επέκταση της πρόσβασης στην περίθαλψη έως την προώθηση των περιβαλλοντικών στόχων, η Purpose for Progress: MSD Impact Report 2024/2025 δείχνει πώς η εταιρεία μας δημιουργεί μετρήσιμο αντίκτυπο — για τους ανθρώπους, τις κοινότητες και τον πλανήτη. Το όνομα ενισχύει τον τρόπο με τον οποίο ο σκοπός μας χρησιμεύει ως πυξίδα και μας καθοδηγεί σε κάθε μας προσπάθεια. Επειδή η πρόοδος δεν συμβαίνει απλώς. Χτίζεται — από ανθρώπους, με σκοπό.
Μετάβαση σε:
Πρόσβαση στην υγεία | Εργαζόμενοι | Περιβαλλοντική βιωσιμότητα | Ηθική και αξίες
Δείτε: Ο αντίκτυπος της εταιρείας μας
Ο αντίκτυπός μας σε αριθμούς
Άτομα που έλαβαν τα φάρμακα και τα εμβόλιά μας το 2024.
Μέλη τουλάχιστον μίας από τις 10 employee business resource groups— σχεδόν το 30% του εργατικού μας δυναμικού παγκοσμίως. Όλοι οι εργαζόμενοι είναι ευπρόσδεκτοι να ενταχθούν σε οποιαδήποτε ομάδα.
Ημερομηνία-στόχος για την επίτευξη μηδενικών εκπομπών αερίων του θερμοκηπίου σε όλες τις παγκόσμιες δραστηριότητές μας (Πεδία 1, 2 και 3), σύμφωνα με τις οδηγίες της πρωτοβουλίας Science-Based Targets.
Διαθεσιμότητα του εργαλείου αναφοράς μας, το οποίο επιτρέπει στους εργαζόμενους και σε τρίτους να εγείρουν ανησυχίες εμπιστευτικά και ανώνυμα (όπου επιτρέπεται από το νόμο).
Η προσέγγισή μας στη βιωσιμότητα
Μέσω μιας συλλογικής και ολιστικής προσέγγισης που αξιοποιεί τη συνεχή καινοτομία, τις στρατηγικές επενδύσεις και τις ισχυρές συνεργασίες, εργαζόμαστε για να επεκτείνουμε την πρόσβαση στην υγεία, να καλλιεργήσουμε ένα εργατικό δυναμικό χωρίς αποκλεισμούς, να ελαχιστοποιήσουμε τις περιβαλλοντικές μας επιπτώσεις και να διατηρήσουμε τα υψηλότερα πρότυπα ηθικής και ακεραιότητας.

Πρόσβαση στην υγεία
Οι καινοτομίες στον τομέα της υγείας έχουν μεγαλύτερη σημασία όταν φτάνουν στους ανθρώπους που τις χρειάζονται. Το 2024, φτάσαμε στο 92% των χωρών του κόσμου με τα προϊόντα μας.

Εργαζόμενοι
Οι άνθρωποί μας βρίσκονται στο επίκεντρο του σκοπού μας. Το 2024, οι εργαζόμενοί μας αφιέρωσαν περισσότερες από 3 εκατομμύρια ώρες στη μάθηση — από πρακτική εκπαίδευση έως ανάπτυξη ηγετικών ικανοτήτων. Επενδύουμε στην ανάπτυξη, την ευημερία και τις ευκαιρίες, ώστε κάθε εργαζόμενος να μπορεί να ηγείται με σκοπό και να διαμορφώνει το μέλλον.

Περιβαλλοντική βιωσιμότητα
Εργαζόμαστε για ένα μέλλον όπου οι άνθρωποι και ο πλανήτης μπορούν να ευημερήσουν. Έχουμε δεσμευτεί να προμηθεύουμε το 100% της ηλεκτρικής ενέργειας που αγοράζουμε από ανανεώσιμες πηγές ενέργειας έως το 2025. Όλα αυτά αποτελούν μέρος του ταξιδιού μας προς την επίτευξη μηδενικών εκπομπών αερίων του θερμοκηπίου .

Ηθική και αξίες
Καθοδηγούμαστε από αξίες και εμπνεόμαστε από ακεραιότητα. Το 2024, περισσότερο από το 99% των εργαζομένων ολοκλήρωσαν εκπαίδευση σε θέματα δεοντολογίας και δαπανήσαμε 4 δισεκατομμύρια δολάρια σε μικρούς προμηθευτές Tier 1 και 2 παγκοσμίως, ενισχύοντας μια υγιή αλυσίδα εφοδιασμού. Έτσι κερδίζουμε εμπιστοσύνη, κάθε μέρα, όπου κι αν εργαζόμαστε.

